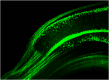

Ultramicroscopy: development and outlook
- PMID: 26730396
- PMCID: PMC4696521
- DOI: 10.1117/1.NPh.2.4.041407
Ultramicroscopy: development and outlook
Abstract
We present an overview of the ultramicroscopy technique we developed. Starting from developments 100 years ago, we designed a light sheet microscope and a chemical clearing to image complete mouse brains. Fluorescence of green fluorescent protein (GFP)-labeled neurons in mouse brains could be preserved with our 3DISCO clearing and high-resolution three-dimensional (3-D) recordings were obtained. Ultramicroscopy was also used to image whole mouse embryos and flies. We improved the optical sectioning of our light sheet microscope by generating longer and thinner light sheets with aspheric optics. To obtain high-resolution images, we corrected available air microscope objectives for clearing solutions with high refractive index. We discuss how eventually super resolution could be realized in light sheet microscopy by applying stimulated emission depletion technology. Also the imaging of brain function by recording of mouse brains expressing cfos-GFP is discussed. Finally, we show the first 3-D recordings of human breast cancer with light sheet microscopy as application in medical diagnostics.
Keywords: brain clearing; light sheet; objective correction; three-dimensional brain imaging; tumor clearing; ultramicroscopy.
Figures

References
Grants and funding
LinkOut - more resources
Full Text Sources
Other Literature Sources